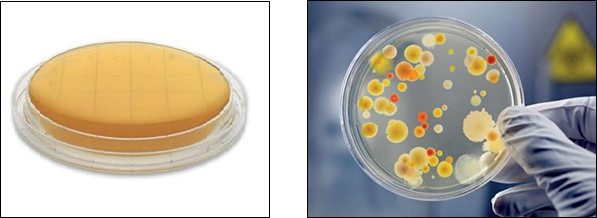

Campionamento dell’aria: metodi e strumenti per monitorare la qualità
Prima di effettuare un campionamento microbiologico in un ambiente di lavoro, è necessario svolgere un sopralluogo per valutare se il tipo di attività lavorativa svolta comporta l’uso deliberato di microrganismi o una potenziale esposizione agli agenti biologici ed individuare le fasi lavorative a rischio.
Si raccolgono tutte le informazioni essenziali per poter stilare un protocollo di campionamento dettagliato, in cui vengono elencati i biocontaminanti da campionare, le tecniche analitiche da utilizzare, la durata del campionamento, il numero e la localizzazione dei siti dove effettuare il monitoraggio.
Nel caso di attività lavorative che comportino un uso deliberato di agenti biologici, si procederà al monitoraggio di tali agenti, che consentirà anche la verifica dell’adozione di corrette procedure operative da parte dei lavoratori e di idonee misure di contenimento ambientale per evitare la diffusione degli agenti biologici.
Per quegli ambienti di lavoro, come quelli indoor (uffici, scuole etc.) per i quali la presenza di agenti potenzialmente patogeni può essere considerata accidentale, la valutazione della carica microbica totale (funghi e batteri) è usualmente sufficiente per la valutazione del rischio di esposizione.
Come noto, in campo biologico non sono disponibili protocolli standard di campionamento e di analisi degli agenti di rischio, né valori limite di esposizione occupazionale.
Poiché nell’aria la maggior parte dei microrganismi presenti è innocua e i patogeni rappresentano una frazione minima, è ragionevole pensare che il contenimento delle concentrazioni microbiche totali al più basso livello possibile, riduca il rischio di esposizione ai microrganismi patogeni.
Come viene eseguita l’analisi dell’aria
L’analisi dell’aria indoor e la valutazione della sua contaminazione viene effettuata mediante il monitoraggio microbiologico ambientale (MMA).
Questa operazione viene eseguita prelevando un campione dell’aria, soprattutto quella in uscita dalle bocchette di ventilazione d’aria e/o dai condizionatori, ed effettuando controlli sulle superfici.
Il campionamento consiste nel prelevare un certo volume d’aria, mediante un mezzo filtrante in grado di trattenere il contaminante.
Nel caso di un campionamento microbiologico, gli agenti contaminanti verranno lasciati a moltiplicare su terreni di coltura solidi o liquidi, in modo da poterle poi numerare ed analizzare.
Esistono due principali metodi di campionamento dell’aria:
- Campionamento attivo;
- Campionamento passivo.
La scelta della tecnica e degli strumenti di campionamento aria da impiegare dipende soprattutto dalla destinazione d’uso di un ambiente interno e dal tipo di inquinanti che si presume possano essere presenti nell’aria.
Ovviamente, dalla scelta della modalità di esecuzione più adeguata dipende anche la qualità dei campioni di aria prelevati.
Una tecnica errata, o comunque non adeguata per un certo ambiente, potrebbe infatti alterare il comportamento dei microrganismi patogeni presenti nell’aria e, dunque, falsare i risultati del campionamento.
In generale, per una procedura di campionamento dell’aria ottimale:
- Il punto di prelievo deve essere localizzato al centro dell’ambiente da monitorare;
- Vanno tenuti in considerazione elementi quali: struttura dell’ambiente, posizione di porte, finestre e fonti di illuminazione, presenza o meno di ricircolo dell’aria;
- Il prelievo del campione deve essere fatto ad almeno 50 cm di distanza dalle bocchette del sistema di condizionamento dell’aria.
Ma vediamo ora nel dettaglio le modalità con cui è possibile svolgere i campionamenti dell’aria indoor.
Campionamento attivo
Al fine di disporre di un documento di indirizzo operativo generale unico e di garantire la comparabilità dei dati acquisiti, sono state definite le Linee guida, ad uso interno, descritte nel documento “Il monitoraggio microbiologico negli ambienti di lavoro. Campionamento e analisi (Seconda Edizione, INAIL 2010)”. Il protocollo prevede il campionamento di volumi noti di aria tramite campionatore attivo ad impatto ortogonale e l’utilizzo di tecniche analitiche di tipo colturale, e il controllo della contaminazione delle superfici, tramite utilizzo di piastre a contatto.
Il campionamento dell’aria avviene utilizzando un campionatore SAS (Surface Air Sistem), sviluppato appositamente per campionare i biocontaminanti aerodispersi come spore, batteri, muffe, lieviti.
L’aria è aspirata a velocità costante, per un tempo variabile noto, attraverso una testata dotata di piccoli fori di speciale conformazione. Il flusso laminare d’aria che ne deriva è convogliato sulla superficie del terreno nutritivo di una piastra Contact (Figura 1) scelto in funzione del tipo di test microbiologico che si intende eseguire. Ultimato il ciclo di campionamento, la piastra Contact è rimossa dal campionatore e trasferita in incubatore. I microrganismi si evidenzieranno al termine dell’incubazione sotto forma di colonie visibili ad occhio nudo (Figura 2), rendendo possibile il loro conteggio (esprimendo la carica batterica come UFC/m3) e la valutazione del livello di contaminazione dell’aria esaminata.

figura 1 Schema di campionamento mediante campionatore SAS
figura 2: piastra di cultura Petri sterile prima del campionamento (sinistra) e dopo incubazione con crescita di colonie batteriche (destra)
Il criterio adottato per esprimere i risultati è di tipo quantitativo, indicativo del potenziale di inquinamento complessivo dell’ambiente considerato. Esiste anche un criterio di valutazione qualitativo volto alla determinazione dei ceppi patogeni ed all’identificazione della loro classe di appartenenza, informando circa la presenza di rischi specifici e/o di fonti di rilascio, la cui identificazione può avere un notevole significato preventivo.
Campionamento passivo
Nel campionamento passivo si espongono nell’ambiente in esame, per opportuni intervalli di tempo, piastre contenenti un idoneo terreno di coltura: su di esse si raccolgono per sedimentazione i microrganismi veicolati da particelle solide o liquide sospese nell’aria.
Il metodo maggiormente utilizzato a livello igienistico è l’Indice Microbico Aria (IMA), il quale esprime il grado di inquinamento microbiologico dell’aria come numero di unità formanti colonia (UFC) che si contano in una piastra Petri di 9 cm di diametro, contenente agar nutriente, lasciata aperta nell’ambiente per un’ora, ad un metro da terra e ad un metro da ogni ostacolo fisico rilevante.
Dopo opportuna incubazione delle piastre, si procede alla conta del numero di colonie cresciute. L’efficienza di raccolta dipende dalle caratteristiche aerodinamiche delle particelle e dal grado di ventilazione dell’ambiente.
Questa tecnica di campionamento, presenta il vantaggio di avere una stima diretta del numero di microrganismi che si depositano sugli oggetti o sugli alimenti presenti, ma ha alcuni svantaggi, tra cui quello di non essere un metodo quantitativo, non permette di correlare il numero di microrganismi a un volume noto di aria ed ha una bassissima sensibilità.
Nel prossimo paragrafo ci concentreremo sull’analisi di alcuni dei campionatori d’aria attivi e passivi più utilizzati.
Campionamento particelle aerodisperse
Pur non essendoci una normativa di riferimento per la determinazione quantitativa del particolato aerodisperso per ambienti di lavoro in cui non si hanno locali a contaminazione controllata (come per le sale operatorie o le camere bianche), il monitoraggio della contaminazione particellare è realizzato al fine di valutare la capacità dell’impianto di condizionamento di minimizzare l’immissione di microrganismi nell’ambiente, considerato il fatto che il particolato polveroso è considerato un “carrier” dei microrganismi eventualmente presenti.
la misura viene effettuata mediante un contatore discreto di particelle (figura 3), conforme a quanto stabilito dalla norma tecnica UNI EN 13205:2002 (dispositivo a diffusione di luce) in grado di: – visualizzare o registrare la conta e le dimensioni delle particelle discrete nell’aria;
– discriminare la dimensione delle particelle in modo da rilevare la concentrazione totale delle particelle appartenenti alla gamma dimensionale considerata.

figura 3: campionatore conta particelle laser
Lo strumento è in grado di misurare la concentrazione di particelle espressa come numero di particelle per metro cubo di aria aspirato, discriminando le particelle per dimensione (0,5 μm, 0,7 μm, 1,0 μm, 3 μm, 5 μm, 10 μm).
La modalità di campionamento prevede che la sonda sia rivolta verso il flusso dell’aria se siamo in presenza di flussi laminari. Per flussi turbolenti, in cui non è possibile stabilire l’esatta direzione del flusso, la sonda deve essere rivolta verso l’alto.
al fine di avere un valore indicativo sul quantitativo di polvere misurata, si può far riferimento alla tabella 1 riportata nella norma ISO 14644-1 : 2015 per la classificazione dei locali a contaminazione controllata (sale operatorie), in cui la classe di pulizia di un locale è stabilita in funzione della concentrazione di particelle, ed è designato da un numero di classe ISO, N. (per sale operatorie valori accettati ISO 5 o ISO 7). per ambienti di lavoro non classificati, si possono utilizzare come valori di riferimento quelli relativi al numero di particelle/m³ relativi ad ambienti ISO 8.

la determinazione del particolato polveroso aerodisperso in ambienti di lavoro, non avendo valori di riferimento, ha un puro aspetto indicativo. tuttavia, può essere utile nello studio e certificazione della bonifica degli impianti di condizionamento, in quanto il numero di particelle immesse dall’impianto a seguito della bonifica cala drasticamente. si può quindi fare un confronto dei risultati ottenuti dal monitoraggio prima della bonifica e dopo la bonifica per dimostrare il reale abbattimento delle polveri immesse dagli impianti all’interno di ambienti indoor.
Quali sono gli strumenti per il campionamento dell’aria
Nel campionamento dell’aria indoor vengono impiegati diversi strumenti che si differenziano per la metodologia utilizzata (attiva o passiva).
Il campionamento microbiologico SAS (Surface Air System) rientra, ad esempio, nel tipo di campionamento attivo.
Il SAS è un sistema molto efficace per il campionamento della qualità dell’aria indoor, perché consente un controllo sia continuo che sequenziale, e di durata variabile da pochi minuti a diverse ore.
Questo tipo di strumento è progettato e realizzato per essere:
- Utilizzabile in ogni ambiente di lavoro;
- Facilmente trasportabile;
- Duraturo, grazie a batterie con ampia autonomia e ricaricabili.
Attraverso l’uso di campionatori di tipo SAS una quantità predefinita di aria viene aspirata e convogliata in un coperchio, sotto cui è presente una capsula di Petri contenente terreno di coltura agarizzato.
Finito il tempo necessario a campionare il flusso d’aria, la piastra di Petri viene rimossa e messa ad incubare, per verificare le colonie di virus e batteri sviluppatesi per UFC/m3 e valutare il livello di contaminazione.
Rientrano invece nel campionamento passivo quei campionatori diffusivi a simmetria radiale, costituiti da un tubo di diffusione, una specie di cartuccia cilindrica contenente carbone attivo o un altro tipo di materiale assorbente.
Questo strumento sfrutta il processo fisico di diffusione degli inquinanti. All’atto del campionamento, la cartuccia viene inserita dentro un corpo diffusivo cilindrico altamente poroso collocato sopra un sostegno.
Strumenti di campionamento passivo come questo appena descritto forniscono valori di concentrazione media, per un tempo più o meno prolungato.
Il campionamento di polveri inalabili e respirabili avviene utilizzando uno strumento chiamato Particle Scan, una sorta di campionatore in grado di stabilire l’esatta quantità delle particelle sospese ed aerodisperse in un ambiente indoor, nonché indicare le fonti inquinanti.
Campionamento dell’aria in un ambiente di lavoro: perché è importante?
La presenza di fonti di inquinamento chimiche e biologiche in ambienti confinati, unita ad una scarsa ventilazione, non solo genera un elevato grado di discomfort, ma costituisce anche una minaccia seria per la salute di chi occupa un determinato ambiente.
Una cattiva qualità dell’aria indoor genera, infatti, quella che viene comunemente chiamata Sindrome dell’edificio malato (Sick building syndrome, SBS), un quadro di sintomi riportati dalla maggioranza dei soggetti che lavorano in un determinato edificio.
Ciò rende estremamente necessario il monitoraggio costante e periodico dell’aria indoor, al fine di garantire una qualità ed una salubrità adeguata al raggiungimento di uno stato di benessere, che avrà effetti positivi anche sulle performance lavorative.



Elabora DVR, gestisci le analisi e organizza le manutenzioni in un posto unico. Un’esperienza straordinaria, affiancato dai migliori esperti Legionella dedicati alla tua azienda.








